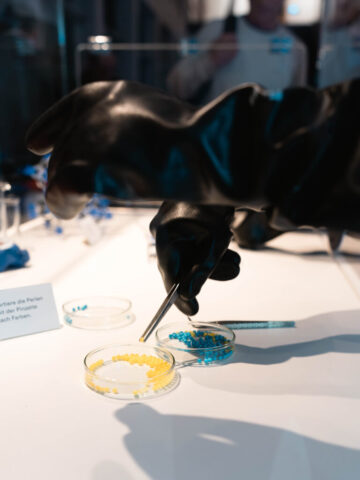

Science Exhibition
From February 11 to 25, 2025, the “Was kann Katalyse?” science exhibition took place at the Stuttgarter Rathaus, as part of the “Wissen trifft Stadt” initiative. Organized in collaboration with the City of Stuttgart, the exhibition focused on catalysis and its role in sustainable science as well as on the research performed within the CRC 1333.
Science Exhibition “Was kann Katalyse?”
The exhibition featured nine interactive displays spread across two floors, complemented by five double-sided lightboxes that provided deeper insights into the showcased concepts. Additionally, three video installations presented five distinct videos, offering valuable perspectives on catalysis, the future of catalysis, the process of catalytic hydrogenation, as well as an overview of CRC 1333 and the crucial role of Simulation & Theory in our research. Six banners, used both as backdrops for the exhibits and as standalone elements, further enriched the exhibition’s narrative.
Part of the exhibits were developed in-house, while others were created in collaboration with the agency VISUELL. The exhibits were all designed with a focus on interactivity, encouraging visitors to actively engage and experience firsthand how catalysis works, as well as gain insight into the work of a chemist.
With a modular exhibit concept, “islands” were created, which, through floor coverings and large-scale banners, formed a scenography that evoked associations with chemistry labs.
Two potential visitor groups were identified:
- school classes from grade 10 onwards and
- the general public with an interest in science.
Both groups were targeted through a comprehensive communication campaign, which included mailings to existing school distribution lists, social media outreach, outdoor advertising (such as pavement barriers and digital city ads), flyers and information to the local press.
The exhibition ran for two weeks and was truly a success:
- 18 school groups were guided through the exhibition (307 students and 20 teachers) – from Stuttgart, Karlsruhe, Heilbronn, the Lake Constance region, and the Swabian Alb region.
- 34 participants attended the two open tours offered to the general public
- 58 attendees joined the evening lecture titled “CO2: Rohstoff für eine nachhaltige Zukunft?” by Jun.-Prof. Deven Estes, which included exciting live experiments with audience participation.
Photo Credit: VISUELL Studio für Kommunikation GmbH
Photo Credit: CRC 1333
Photo Credit: CRC 1333
We are proud of the positive feedback we received and the meaningful connections made throughout the exhibition. It was a fantastic opportunity to engage with the public and raise awareness about the importance of catalysis in shaping a sustainable future as well as educating the society about our research.
Thank you to everyone who participated and helped make this event a memorable success!